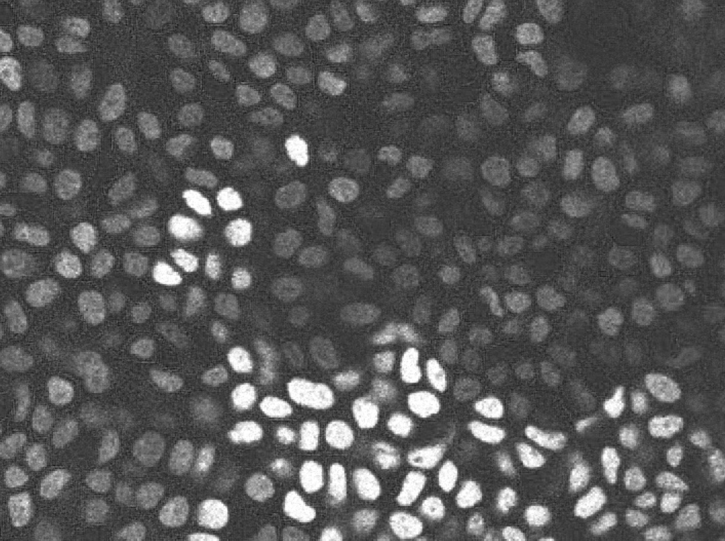
Image credits to Professor Katie Cockburn McGill University, Canada.

As a genetics scientist at Yale University, I spend my days shining lights on skin cells. By changing illumination, my team and I reveal cell shapes, differences, relationships, and hidden components within the same organ.
No single image tells the whole story. Each reveals something different, and each obscures something else. Putting these images together allows us to understand better how living systems function.
Increasingly, I see the same dynamics beyond the microscope and in the academic community. Some people are seen; some are emphasized; some are erased.
Expanding our understanding requires bringing together individuals with diverse experiences, so that we can extend our “in-sight” beyond familiar characteristics and more fully recognize the range of people and ideas that sustain discovery.
Differences in Visibility
In the image below, circular cells show different levels of brightness; some appear white, some gray. The difference comes from how much each cell received of a fluorescent tag, a tiny piece of DNA that acts like a bulb.
Though the cells appear unevenly bright, they all play a role in keeping the skin intact and functional. Brightness does not equal importance; it reflects exposure.
Similarly, in my academic community, we tag each other based on characteristics we have learned to consider more or less shiny: gender, race, abilities, alma mater, areas of research. Academic culture selectively amplifies certain characteristics while muting others.
Each of us contributes to our shared mission, yet some are far more illuminated than others.
How Filters Change the Story
When the filter shifts to blue, such as in the images below, many cells become harder for the human eye to see. What disappears does not cease to matter; it ceases to be part of our understanding.

The same is true in academia. Attention and reward gravitate toward individuals who are most visible to us. Others, despite their contributions, fade into the background.
For example, people of all genders regularly make scientific discoveries. Yet the discoveries attributed to men are narrated far more often than those attributed to others.
Earlier in my own career, I received a prestigious award alongside four other professors — another who identified as a woman and three who identified as men. A journalist interviewed each of us about the work behind the award. The final article included eight verbatim quotes: one from the women, and seven from the men.
The light of journalistic recognition shone disproportionately on those who identified as men, shaping whose voice became authoritative in the public record.
This imbalanced attention reflects not simply individual bias, but a cultural filter shaped over generations. Thus, we focus on a few, not because others matter less, but because the filter narrows what we notice.
Unseen Connections
When cell boundaries are highlighted in green, relationships emerge. Connections appear not only among the brightest cells but also among those previously overshadowed.

For generations, the contributions of women and other structurally marginalized scientists to scientific discoveries have gone unseen and unacknowledged. The discovery of the structure of DNA, for example, is often told as the achievement of two men, despite the fact that the model relied critically on data produced by Rosalind Franklin, a contemporary woman scientist.
That the woman was omitted from the story is not an exception; it is a recurring feature across scientific fields.
When connections are obscured, the nature of discovery itself is misunderstood. Scientific advances, like healthy cellular functioning, emerge through relationships among people, ideas, and labor, not through isolated brilliance.
When we erase contributors, we do not simply misassign credit; we distort how knowledge is produced.
The Unnarrated

In the image above, a new red tag reveals black spots that were previously invisible. These dark cells were always present, but without the right combination of light and contrast, they remained hidden.
Absence from view is not absence from reality, though.
Failing to see both the unseen cells and their connection to the whole sets us back in understanding how cells and organs work. For instance, fertility studies have long held a narrow focus on the egg. Multiple other environmental factors, such as other cell types and the connective tissue of the ovary, are now shown to be critical to the fertilization process. Our previous fixation on the autonomy of the egg rested on our inability — or unwillingness — to take into account the other cellular players that support the egg’s health.
This pattern is mirrored in the social world. Many people’s realities remain unnarrated. We have learned not to notice or take their realities seriously because of how we see them. Their stories would deepen our understanding of our shared world, but because we have not chosen the lights that would reveal them, our understanding remains incomplete.
Choosing Our Lights
For me, the question is no longer whether the academy’s understanding of talent, contribution, and potential is incomplete; it always is. The question is whether we as a community are willing to choose lights that allow us to see others, and to see more fully. When we fail to do so, the consequences are real: loss of talent, narrower questions, and slower scientific progress.
Fortunately, my work teaches me that visibility is not fixed: it is produced. Everyone has the potential to be either seen or unseen. Whether we are studying cells or human communities, our understanding deepens when more lights are brought in.
This realization turns my attention inward, and I ask myself: What new lights do I need to turn on to see what I have overlooked and whom I have failed to see?


